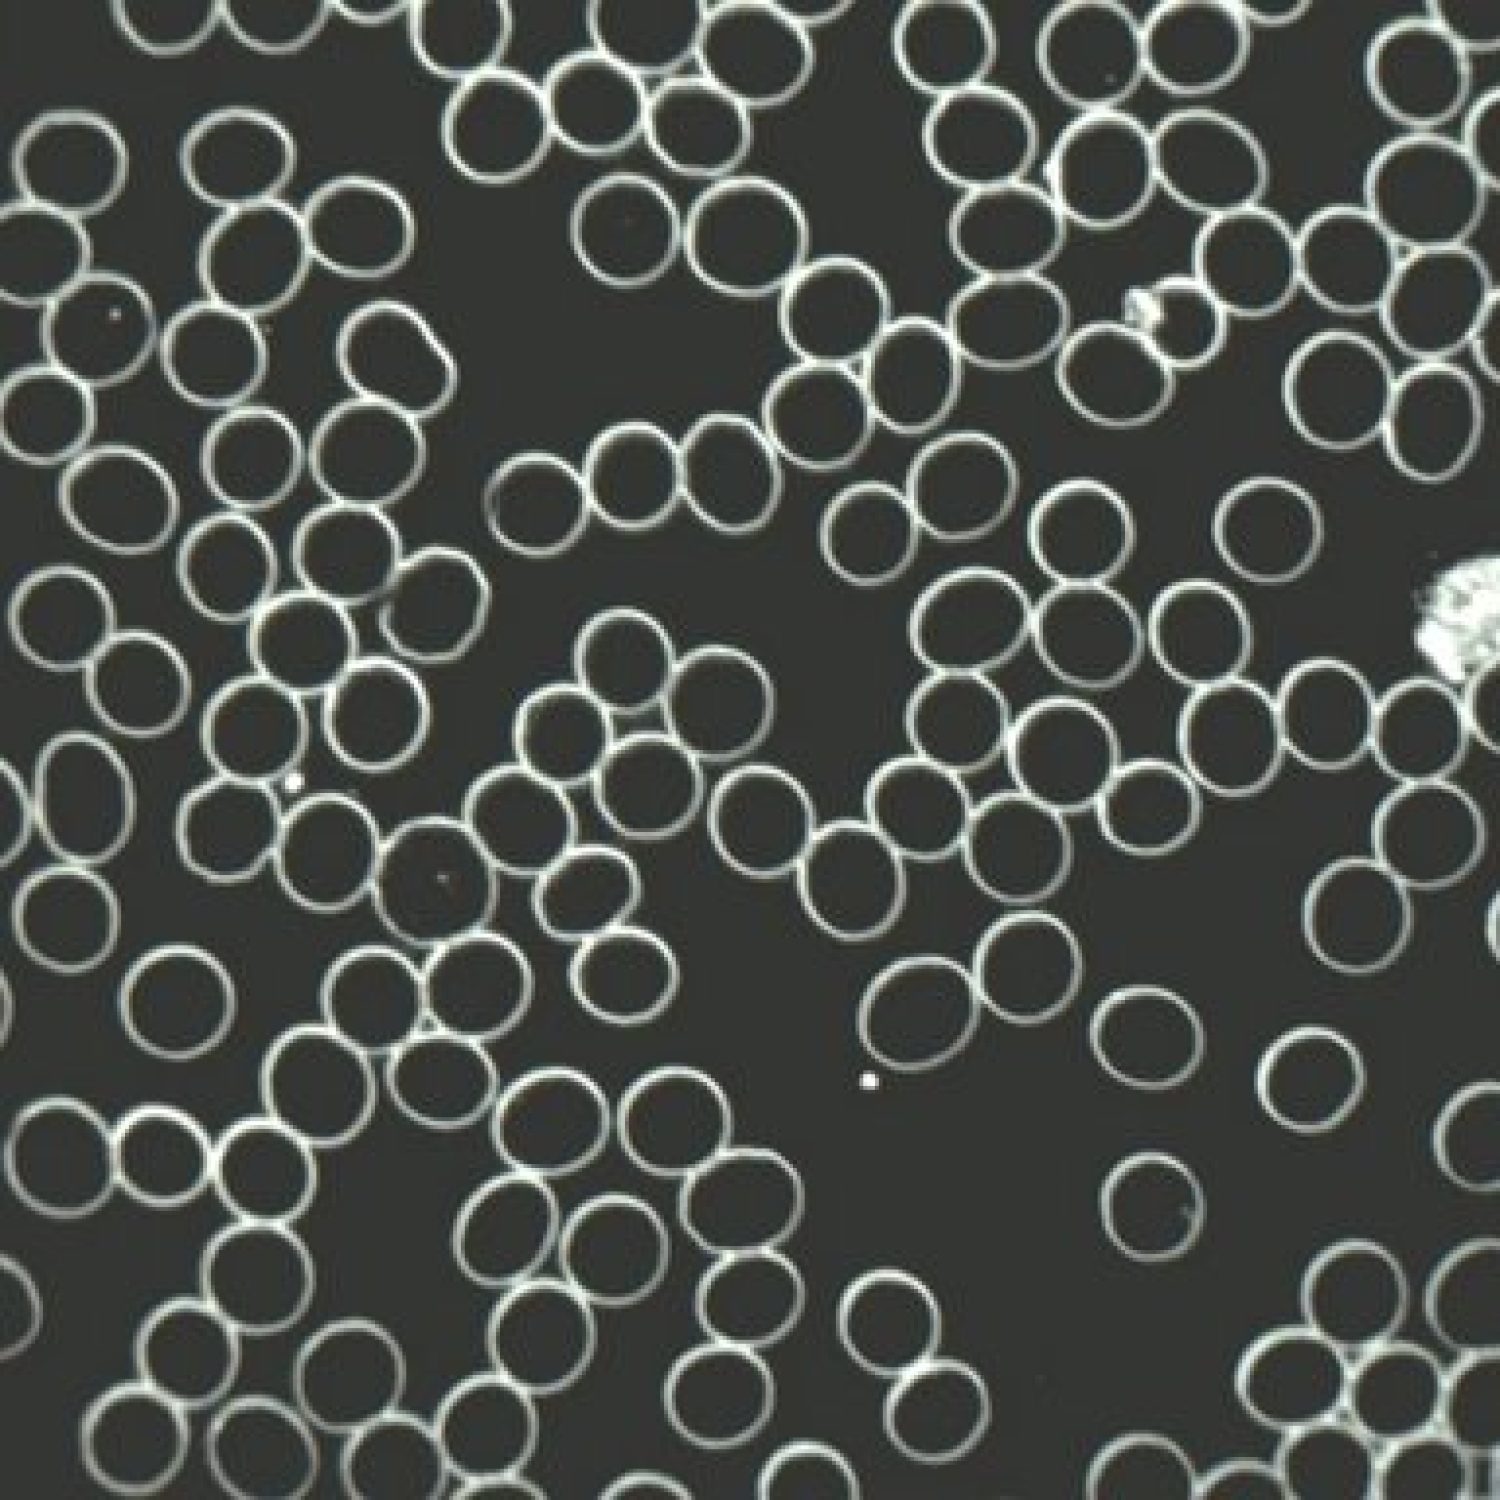
Levend Bloed normaal beeld

Heb ik een vitamine tekort?
Regelmatig vragen patiënten mij of ik kan constateren of er misschien tekorten zijn aan bepaalde stoffen (zoals bijvoorbeeld vitaminen en mineralen) of wat de oorzaken zijn van bijvoorbeeld spijsverteringsproblemen. Om hier inzicht in te krijgen werk ik met de Bodyscanalyzer.
De Bodyscanalyzer werkt op basis van elektromagnetisme en scant in korte tijd alle belangrijke lichaamssystemen en stoffen in het lichaam en geeft eventuele afwijkingen aan.

Bodyscanalyzer
De volgende onderdelen van het lichaam kun je zien met de Bodyscanalyzer:
- Hormoonbalans (vrouwelijke en mannelijke hormonen, stresshormonen en bijnierfunctie)
- Mate van chronische stress
- Gevoeligheid voor diabetes
- Status van vitaminen/ mineralen/ aminozuren/ enzymen
- Effectiviteit van organen (longen, maag,darmen, nieren, lever/gal, pancreas, schildklier, hersenen)
- Hart- en vaatstelsel
- Bewegingsapparaat

De scan hoort bij de behandeling en wordt naar behoefte ingezet. Het is een hele mooie manier om de voortgang van een behandeling te monitoren.
Levend en Droog Bloed Analyse
Wat is Levend Bloed Analyse?
Ons bloed stroomt door ons hele lichaam en geeft waardevolle informatie over onze gezondheidsstatus.
Voor de Levend Bloed Analyse wordt een klein druppeltje bloed uit de vinger onder de microscoop gelegd. Uit dat kleine druppeltje kunnen we met behulp van donkereveld microscopie beoordelen hoe de kwaliteit van het bloed is en daarmee krijgen we een indicatie van je gezondheidsstatus.
Wat is er in het bloed te zien?
Het is fascinerend wat er allemaal in het bloed te zien is. Je kunt meekijken op het beeldscherm en ik leg alles uit.
We zien rode bloedcellen die worden beoordeeld op vorm, de afmeting en hoe ze zich gedragen. Daarnaast kijken we naar hoe bloedplaatjes zich gedragen en bij de witte bloedcellen kijken we naar de hoeveelheid, soort en de activiteit.
Naast rode- en witte bloedcellen kijken we ook naar het plasma, de vloeistof waarin rode en witte bloedcellen vervoerd worden. Dit hoort schoon te zijn, maar er kunnen zich allerlei afwijkingen voordoen zoals parasieten, bacteriën, kristallen, schimmel, fibrine en cholesterol.

Droog Bloed Analyse
Droog Bloed Analyse
Met de Droog Bloed Analyse kijk ik naar de manier waarop de bloeddruppel stolt. Dit geeft informatie over degeneratieprocessen en vrije radicalenstress in je lichaam.
Een overschot aan vrije radicalen in je lichaam geven een grotere kans op ongecontroleerde celdelingen, snellere lichaamsverouderingen en gezondheidsklachten. Een overschot aan vrije radicalen kan verschillende oorzaken hebben zoals infecties en ontstekingen maar kan ook het gevolg zijn van een ongezonde levensstijl.
Heb je geen specifieke klachten maar wil je gewoon weten hoe je gezondheidsstatus is? Dan kan de Levend en Droog Bloed Analyse samen met de Bodyscanalyzer ook apart gedaan worden als algemene gezondheidscheck
NB: De bodyscanalyzer en de Levend en Droogbloed analyses vallen niet onder reguliere diagnostische methodiek